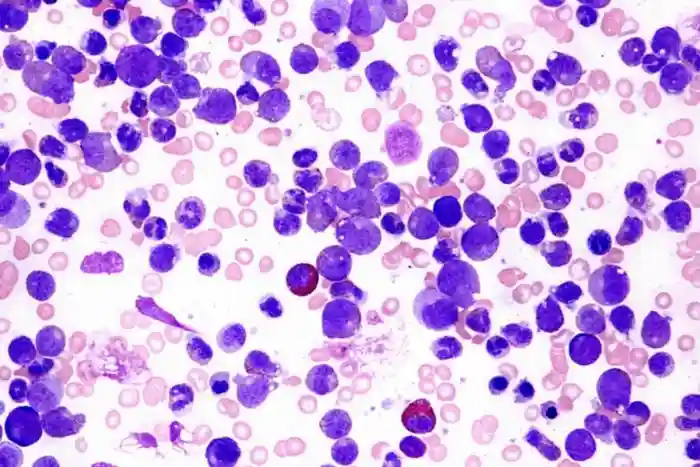

急性骨髓性白血病(AML)导致的骨髓衰竭是该疾病高发病率和死亡率的重要因素。以前在小鼠身上的研究表明,AML细胞会抑制健康的造血(血液)干细胞和祖细胞(HSPC)。发表在《STEMCELLS》上的一项研究通过显示分泌的细胞因子,特别是一种叫做转化生长因子β1(TGFβ1)的蛋白质可导致人类健康血细胞的生产中断(一个叫做造血的过程),从而增加了这一程度的知识。
研究表明,阻断TGFβ1可以改善AML患者的造血功能。
尽管急性髓细胞白血病只占所有癌症的1%左右,但据美国癌症协会称,它是诊断出的第二种最常见的白血病类型。AML影响血液和骨髓--骨骼内制造血细胞的海绵状组织。死亡率很高--对于20岁及以上的人来说,五年的生存率是令人沮丧的26%。
AML的发展机制尚不完全清楚,但一般认为它开始于造血干细胞或祖细胞,这些细胞发展成骨髓细胞,进而成为红细胞、白细胞或血小板。杜塞尔多夫海因里希·海因大学的研究人员进行的这项最新研究旨在调查白血病细胞分泌的液体在抑制健康造血干细胞和HSPC的生长方面可能发挥什么作用。


之前已经进行了使用AML细胞的条件培养基(CM)来解决分泌机制的实验,但主要是在小鼠身上。该研究的通讯作者、血液学、肿瘤学和临床免疫学系的ThomasSchroeder博士说:"为了深入了解这种情况在人类身上是如何发生的,我们使用一个体外系统模拟体内AML细胞浸润骨髓的情况,重点研究白血病细胞和健康HSPC之间的互动。这是通过将健康骨髓衍生的CD34+HSPC暴露在来自AML细胞系和新诊断的AML患者的上清液中而实现的。CD34是人类造血干细胞的一个标志,而上清液是细胞分泌的产物)。我们的研究结果显示,暴露在来自AML的上清液中会显著抑制健康CD34+造血干细胞的增殖、细胞循环、集落形成和分化。进一步的实验确定,白血病细胞诱导健康HSPC的功能抑制,至少部分是通过TGFβ1。阻断TGFβ1途径是可以用一种TGFβ1抑制剂(如SD208)在药理学上完成的事情。我们的数据表明,这可能是一种改善AML患者造血功能的有希望的方法。"
STEMCELLS杂志主编JanNolta博士表示,在AML细胞抑制正常造血这一令人困惑的问题上,寻找可能的干预因素是非常重要的。靶向TGFβ1以允许正常干细胞和祖细胞扩展的可能性是未来治疗的一个有希望的线索。